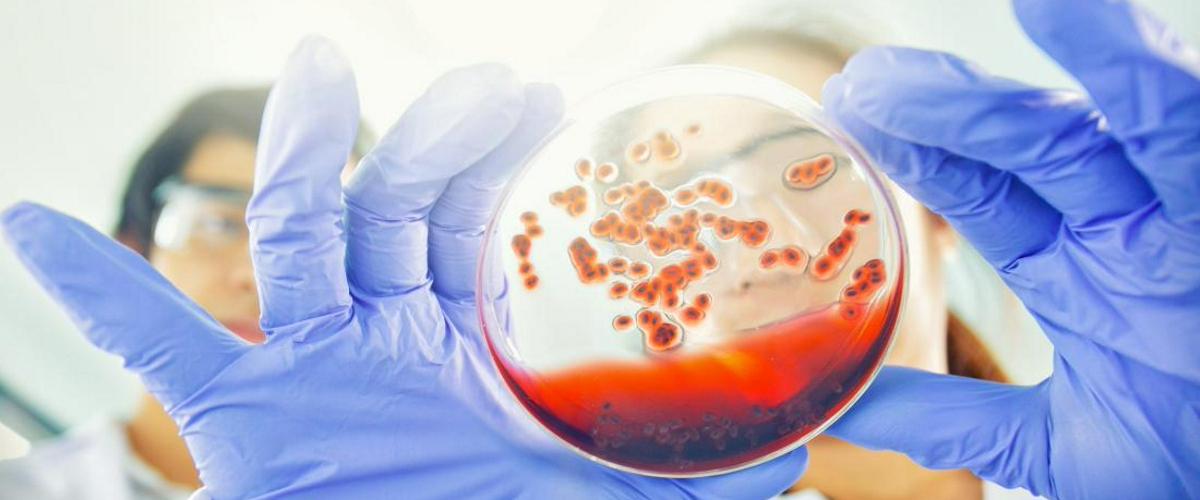
TODO:

Ученые пришли к выводу, что микробиота в кишечнике и коронарных артериях человека может дестабилизировать состояние коронарных бляшек и вызвать сердечный приступ, пишет EurekAlert. Новое исследование показало, что в отличие от бактерий кишечника, микроорганизмы в коронарных бляшках у пациентов с сердечно-сосудистыми патологиями были провоспалительными.
Команда анализировала биологический материал 30 пациентов с острым коронарным синдромом и 10 здоровых добровольцев. Ученые обнаружили, что в отличие от кишечных, коронарные бляшки в основном содержали микробы с провоспалительными фенотипами, относящиеся к бактериям семейств Proteobacteria и Actinobacteria.
Это говорит об избирательном удержании этих бактерий в бляшке. И в дальнейшем они могут спровоцировать воспалительную реакцию и разрыв бляшки, объясняют ученые.
Сравнение микрофлоры между двумя когортами испытуемых также выявило различия в составе микроорганизмов. «Различные химические вещества, выделяемые этими бактериями, могут повлиять на дестабилизацию коронарной бляшки и со временем спровоцировать сердечный приступ», — считает автор исследования Евгения Пизано.
Пока нельзя утверждать, что инфекции и последующие воспалительные процессы непосредственно влияют на коронарные бляшки. Зато выводы открывают новые горизонты для изучения. Теперь ученые намерены оценить возможности различных антибиотиков для предотвращения патологических сценариев у людей.
Дисбаланс в микробиоме кишечника провоцирует развитие многих болезней. Чтобы решить эту проблему, американские ученые предложили новую стратегию реконструирования состава недостающих или избыточных микроорганизмов.